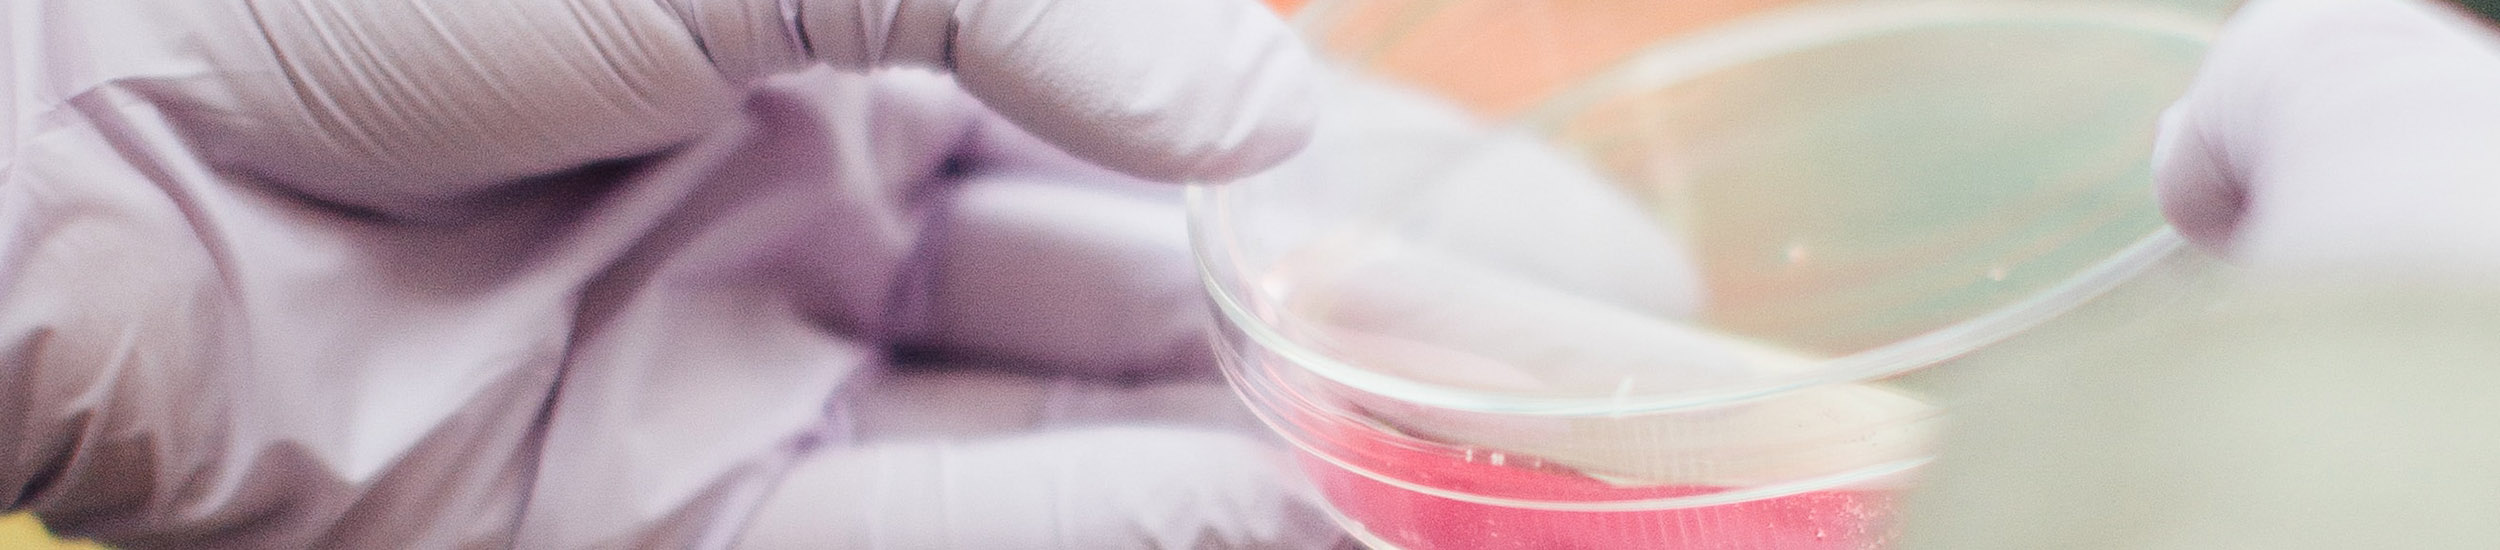

Quality
AHV offers a full-service concept for optimal animal health, whereby all AHV Solutions are developed by our Research and Development (R&D) department. They are manufactured in-house in our AHV Production & Distribution Hub in the Netherlands. In this way, we can warrant and preserve the highest quality possible, as well as maintain flexibility, efficiency and fast delivery times.
We test all of our products thoroughly, both in vitro in our external laboratories, and in vivo at our AHV Farms. This means that we can guarantee high-quality components in combination with extensive testing processes and the operational reliability of the solutions delivered.
Once our solutions have passed the full development process, our team of experienced Animal Health Advisors are ready to bring them directly to your farm and to provide you with good advice.
No matter which unique animal health challenges you are facing in your business, our advisors and their veterinary support teams always have – or will find – the right solution.
Assurance
Our longstanding veterinary, farm and field experience, alongside our certified Production Quality Assurance System gives us the opportunity to develop, produce and distribute our AHV Solutions that meet our high standards in quality and safety.
To guarantee quality and safety for you as a user and worldwide, the AHV Solutions meet a variety of standards for different parts of the world. The quality of AHV Solutions is also guaranteed by analyses of products by accredited laboratories in the development, production and final stages.
AHV International has registration according to the Feed Hygiene Regulation (EC) 183/2005 and assurance according to the following standards: